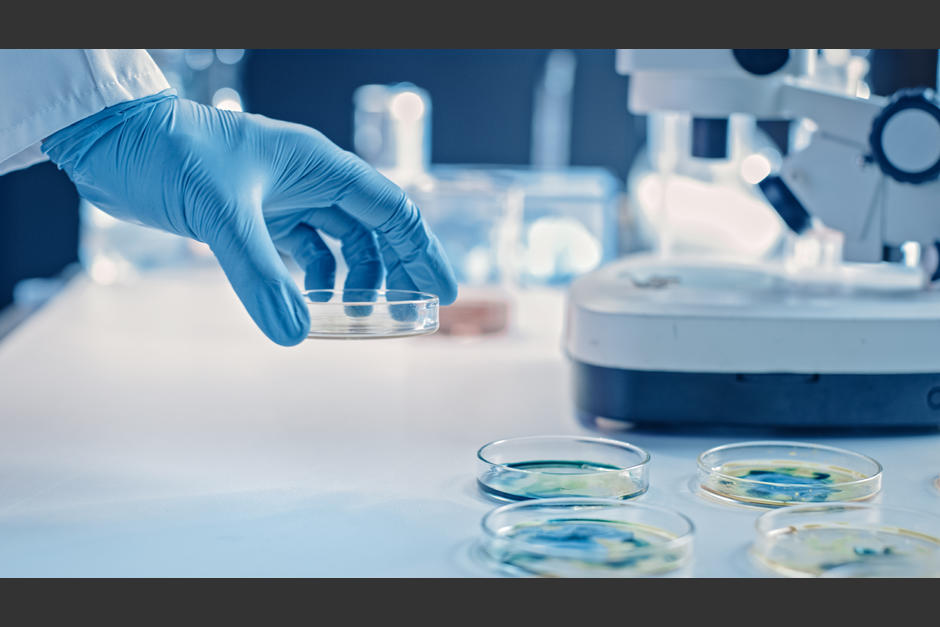
Los hallazgos sobre la c&eacute;lula maligna que se desprenden del c&aacute;ncer de colon fueron hechos por un grupo de investigadores de Europa. (Foto ilustrativa: Esteve.org)

Los hallazgos sobre las células malignas que se desprenden del cáncer del colon han sido alentadoras para encontrar un tratamiento.
OTRAS NOTICIAS: Esta es la postura ideal para dejar de roncar y dormir bien
Según una publicación realizada por el diario "El País", un grupo de científicos europeos descubrió cuales son las células malignas que se desprenden del cáncer de colon, mismas que provocan muertes por metástasis.
El estudio liderado por el biólogo español Eduard Batlle, señala que el 90% de muertes por cáncer se derivan por metástasis, que se trata de aquella propagación de células tumorales que se esparcen por todo el cuerpo.
Cabe destacar que estas células malignas eran indetectables con la medicina o métodos tradicionales.
Tras los nuevos e impresionantes hallazgos, se ha dado a conocer que serán sometidas a estudios, para así poder encontrar tratamientos que sean efectivos y acordes para tratar la metástasis.
Datos sobre la investigación
Por su parte, Batlle explicó que su equipo de trabajo logró el hallazgo gracias a un poro microscópico.
"Estamos investigando si este tipo de células también existe en otros tumores. De hecho, estas células tienen similitudes genéticas con las del cáncer de páncreas más agresivo", señaló Batlle.
La investigación resalta que estas células que fueron denominadas por el equipo de investigación como una "alta probabilidad de recaída", permanecen en otros órganos, como el hígado o el pulmón.
El biólogo también se mostró optimista ante esta investigación, pues mencionó: "Aproximadamente medio millón de pacientes de cáncer de colon al año podrían ser susceptibles de ser tratados con una terapia que prevenga las recaídas".

*Con información de El País.